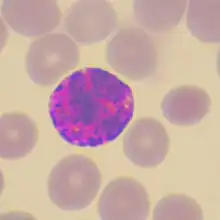

Coloration de May-Grünwald Giemsa
La coloration de May-Grünwald Giemsa, parfois également appelée coloration de Pappenheim est une méthode de coloration utilisée notamment en hématologie pour différencier les cellules du sang lors des préparations cellulaires (cytologie). Les colorations de May-Grünwald, Giemsa, Leishmann sont des variétés de la méthode de Romanowsky (médecin russe, 1861-1921).
Principe de la coloration
Il repose sur l'action combinée de deux colorants neutres :
- Le May-Grünwald, contenant un colorant acide, l'éosine, et un colorant basique, le bleu de méthylène.
- Le Giemsa, contenant lui aussi de l'éosine, et un colorant basique, l'azur de méthylène
Ces deux colorants sont en solution dans l'alcool méthylique sous forme inactive. Lors de l'addition d'eau, les sels précipitent (éosinate de méthylène et azur de méthylène) et se fixent sélectivement sur les constituants cellulaires.
- Les constituants cellulaires acides, fixeront électivement les colorants basiques. Ces éléments sont qualifiés de basophiles (ADN, cytoplasme des lymphocytes riche en ARN).
- Les constituants cellulaires basiques, fixeront électivement les colorants acides. Ces éléments sont qualifiés d'acidophiles ou d'éosinophiles (cas de l'hémoglobine, protéine basique contenue dans les hématies et des granulations des granulocytes éosinophiles).
- Les constituants fixant les deux types de colorants sont dits neutrophiles.
Résultat :
- Les noyaux sont de bleu à violet-noir
- Les hématies sont beige-rosé,
- les granulations des granulocytes éosinophiles sont orangé.
- Les granulations des granulocytes neutrophiles sont violet-lilas.
- Les granulations des granulocytes basophiles sont bleu-noir
- Les granulations des grands lymphocytes sont pourpres.
Particularités
Deux types de comportement des colorants coexistent dans cette coloration :
- Coloration orthochromatique : le colorant garde sa couleur une fois fixé sur le constituant cellulaire (cas de l'éosinate de méthylène : couleur orange de l'éosine conservée, couleur bleue du bleu de méthylène conservée ).
- Coloration métachromatique : le colorant change de couleur une fois fixé sur le constituant cellulaire (cas de l'azur de méthylène bleu qui devient pourpre une fois fixé sur les constituants azurophiles).
Les dilutions des colorants et les rinçages doivent être faits avec un tampon pH 7 ( eau neutre) afin de ne pas perturber les affinités tinctoriales des constituants cellulaires.
Technique
Le mode opératoire ci-dessous est donné à titre indicatif. Il doit être adapté selon les spécifications du fabricant.
Fixation
Il faut d'abord fixer les cellules sanguines présentes sur le frottis. Pour cela placer le frottis horizontalement dans une boîte de coloration et verser 15 à 20 gouttes de colorant May-Grünwald de façon à recouvrir totalement la lame. Attendre 2 à 3 minutes pour que le méthanol fixe les cellules.
Coloration May-Grünwald
Ajouter autant d'eau neutre qu'il y a eu de colorant, laisser agir deux minutes et rincer la lame à l'eau neutre.
Coloration au Giemsa
Diluer le Giemsa immédiatement avant l'utilisation en le diluant au 1/10 (1 volume de Giemsa et 9 volumes d'eau neutre) dans une éprouvette. Verser le contenu dans une boîte de Laveran dès que la lame est prête et mélanger en agitant doucement (le pouvoir du colorant est maximal au moment du mélange). Poser la lame, face frottis vers le fond de la boîte de Laveran. Laisser agir 20 min et rincer à l'eau distillée.
Séchage
Laisser la lame sécher à l'air. Attendre le séchage complet avant observation au microscope.
Observation
| Granulocyte éosinophile | Granulocyte basophile | Monocyte |
|---|---|---|
![]() Granulocytes neutrophile(haut) et éosinophile (bas) |
![]() Granulocyte basophile |
![]() Monocyte |
Voir aussi
Autres techniques de coloration :
- Portail de la médecine
- Portail de l’hématologie